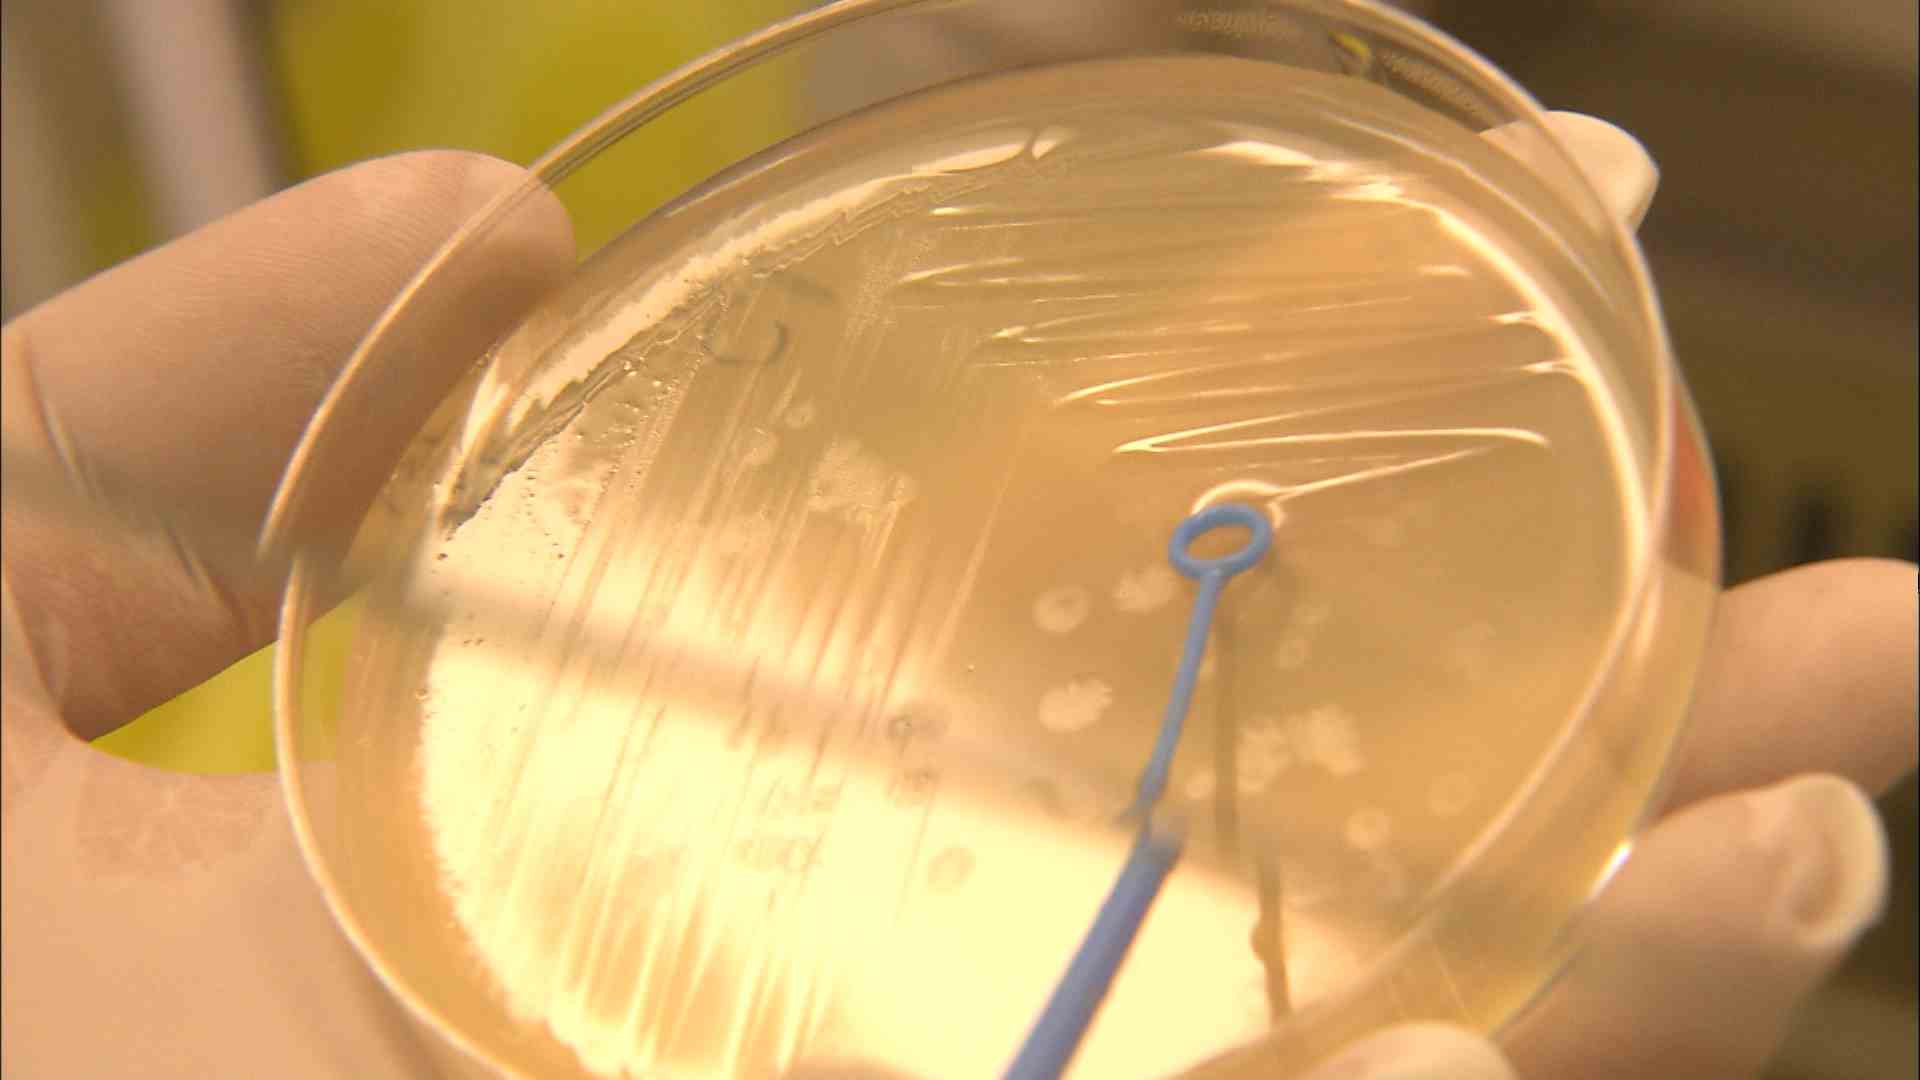

식품 소비가 늘어나는 설 명절을 앞두고 식품 안전 점검이 실시됩니다.
울산시 보건환경연구원은 내일(1/6)부터 나흘 동안 지역 전통시장과 백화점, 대형마트 등에서 유통되는 제수용 식료품을 대상으로 식중독균과 잔류 농약 검사 등을 진행한다고 밝혔습니다.
연구원은 부적합 제품을 즉시 회수해 폐기하고 시중에 유통되지 않도록 조치할 예정입니다.
Copyright © Ulsan Munhwa Broadcasting Corporation. All rights reserved.
취재기자
choigo@usmbc.co.kr